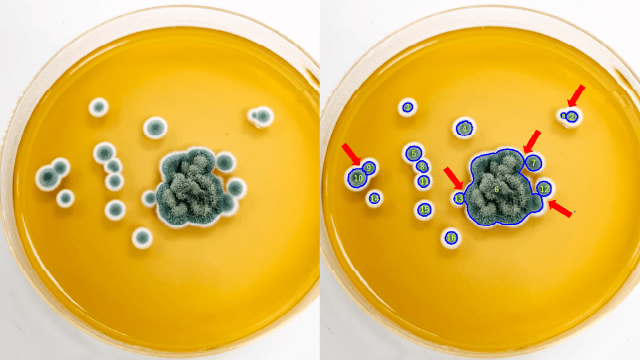

教職員・学生向け 画像解析ソフトウェア
- シリーズ導入実績全国10,000本以上!
- 名作画像解析ソフトWinROOFシリーズが
- 月額換算9,900円(税込)
で使えます! - ※最低契約期間は1年間となります
顕微鏡 / マイクロスコープ、デジタルカメラ /
スマートフォン、SEMなどの画像解析に最適!
他社サービスとの比較
Education
特に粒子分離認識技術に優れる。
レコードマクロ形式で手順を記録するノーコード型ソフト。
(月額換算)
有償ソフト
自動化可能なソフトでもプログラム知識が必 要な場合が多い。
(月額換算)
無償ソフト

画像解析にできること
画像解析とは具体的にどのような技術なのか
例えば、このようなことを想像してみてください。
『顕微鏡をのぞきながら数千個の細胞を目でカウントする』
『モニターに映し出された映像の微妙な色合いの違いを経験だけで見分けている』
想像しただけで大変そうな作業ですよね。しかし、こういった作業は様々な分野で実際に行われていいます。こういった課題を解決するための技術の一つが画像解析です。
画像解析という言葉は非常に難しく聞こえるかも知れませんが、一言で表すと『画像から欲しい情報を取り出す技術』になります。カメラに代表される撮影機器が目まぐるしい進化を続けており、綺麗な画像がより簡単に撮影できるようになるにつれ、『この画像からこんなことが分かったら便利なのに!』というニーズはどんどん多くなっています。
画像解析ではフィルター処理や2値化、パターン認識などの様々な画像処理技術を組み合わせることで、画像から瞬時に細胞のカウントをしたり、研究開発品の欠陥検査、金属や化学材料の評価といった様々な課題を解決することができます。また、画像処理技術を使うことだけが画像解析ではありません。サンプル撮影するための顕微鏡やレンズやマイクロスコープ、デジタルカメラやスマートフォンで綺麗な画像を撮影することや、撮影した画像上で実際に寸法計測を行うことも画像解析に含まれます。




画像解析の活用方法はどのようなものがあるか
画像解析は製造業の品質管理や製品開発、バイオ研究の顕微鏡観察、医療現場での診断支援、大学等の教育研究機関における様々な研究・講義など、産業から研究用途まで非常に多くの方々に利用されている技術です。
例えば、産業分野では、
・製造品の寸法測定検査、ゴミや汚れなどのコンタミネーションの検査
・半導体ウェハーやチップの欠陥検査
・金属や樹脂表面の分析評価
・3D形状の解析
・食品ラインでの異物混入
・液体中の気泡や異物の検出
・肌の角質の評価
バイオ・医療分野では
・がん細胞や病原菌の検出やカウント
・精子の生死判定
・レントゲン画像の画質改善
・細胞の行動分析
・細菌の繁殖度合いの検査
・細胞中のたんぱく質評価シグナルの定量化
パッと思いついたものを書き出すだけでここでは書ききれないほどのテーマがあります。顕微鏡やレーザー測定機、X線CT/MRI、電子顕微鏡(SEM)/TEM/AFMなど様々な撮影装置が利用されている現場で活用されています。人が行うには多くの時間を要し、見間違いや数え間違いを防ぐためにも非常に重要であり、作業効率の向上や省力化といった面でも大きな効果があります。
なかでも教育研究機関での研究は多岐に渡り、かつ先進的です。研究のみならず講義でも画像処理・画像解析を扱う必要性が増しております。そのような方々向けに我々は、最適なコストパフォーマンスを誇る『サブスクリプション型画像解析ソフトウェア WinROOF Education』をご用意しております。
フリーソフトウェアとは異なる「洗練された」「けれども安価な(安い)」先端的画像解析ソフトウェアを是非お手元でご活用ください。